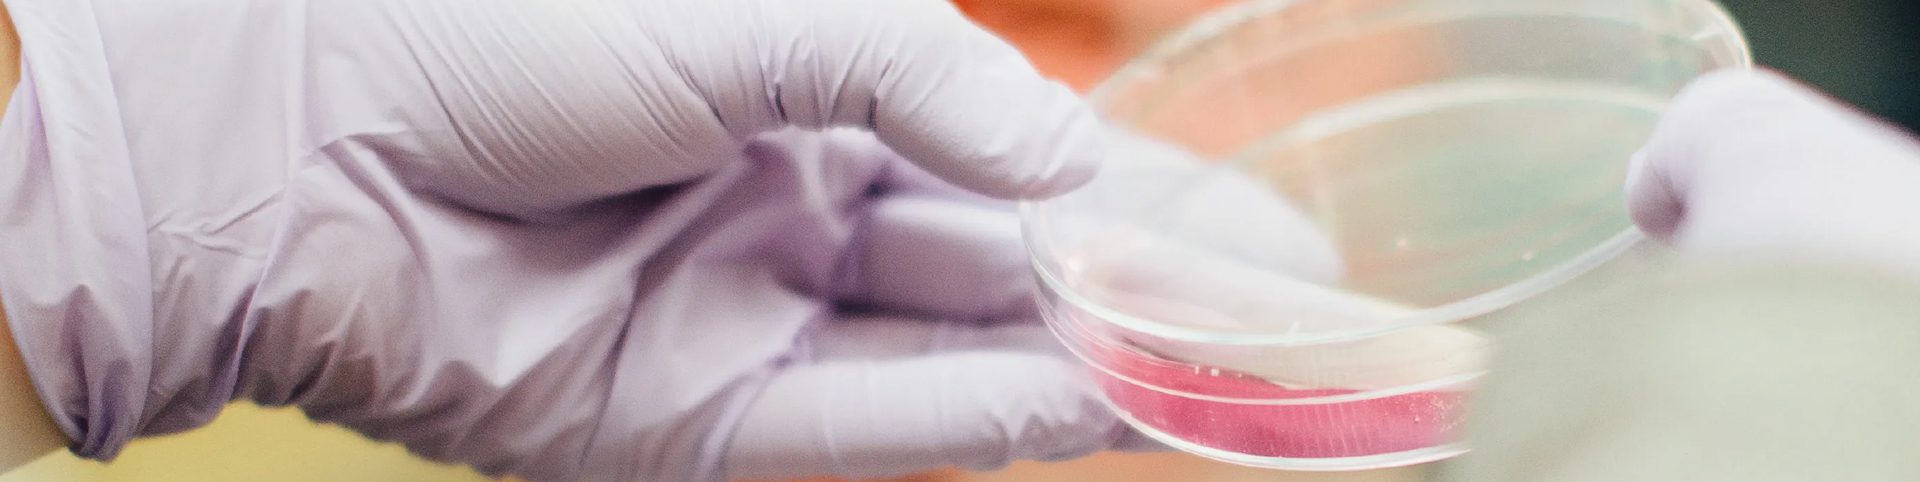
公司簡(jiǎn)介

1. Technical service
We are responsible for arranging technical personnel to the site for installation and commissioning, and responsible for training until acceptance.
2. Technical training
We are responsible for the buyer's technical personnel to carry out product principle, operation, equipment repair and maintenance
And other technical training on site until the buyer's technicians can work independently.
3. After-sales service
The whole machine warranty period is one year after the acceptance of the equipment.
Only materials are charged for maintenance after the warranty expires.
From the time of receiving the user's repair report, our engineers will reply within 24 hours and work out the maintenance plan.